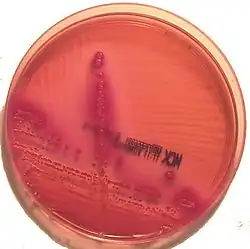
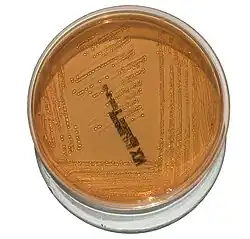

Gélose MacConkey

La gélose MacConkey est un milieu de culture sélectif et différentiel employé en microbiologie pour l'isolement et l'identification des bacilles Gram négatifs (BGN). Ce milieu comporte un double système indicateur qui détecte la consommation du lactose. Développé dans les années 1900 par A.T. MacConkey (en) pour faciliter l'identification de Escherichia coli dans les eaux, les sols et les aliments[1],[2], il est amélioré deux ans plus tard par A.S. Grünbaum et E.H. Hume dans une nouvelle formulation plus sélective et dotée d'un indicateur plus sensible[3].
Ce milieu de culture est très couramment utilisé pour isoler les BGN non exigeants dans toutes sortes de prélèvements polymicrobiens d'origine clinique (plaies, urines, selles, hémocultures)[4],[5], alimentaire[6] et environnementale[7].
Principe
La base nutritive se compose de lactose et de peptone en proportions 1:2. MacConkey emploie 15 ou 20 g/L d'une peptone non spécifique[1],[2]. Certaines formulations actuelles préfèrent un mélange de peptone pancréatique de gélatine, peptone pancréatique de caséine et peptone peptique de viande.
Le milieu est rendu sélectif à l'aide de deux inhibiteurs qui s'opposent à la croissance des bactéries Gram positives. La formule d'origine ne comportait qu'une forme impure de glycocholate de sodium dont l'auteur suppute qu'il était en fait mélangé à du taurocholate de sodium[1]. Ces sels biliaires n'inhibent pas la croissance des BGN « entériques » car le biotope habituel de ces bactéries, le tube digestif des animaux homéothermes, en est naturellement imprégné. Le violet de gentiane est un ajout ultérieur inspiré de la composition de la gélose Drigalski[3] et permettant d'inhiber plus efficacement les Entérocoques[5]. La croissance des bactéries exigeantes (par ex. certains cocci Gram négatifs tels que les Neisseria) est passivement inhibée par les carences nutritionnelles du milieu (absence de facteurs de croissance spécifiques).
La consommation du lactose est détectée à l'aide de deux indicateurs qui réagissent à l'acidification causée par l'accumulation des sous-produits de dégradation de ce glucide. La formule originale de MacConkey fait un double usage des sels biliaires, qui outre leur rôle inhibiteur servent aussi d'indicateur de pH grâce à leur aptitude à précipiter en milieu acide, mais cette réaction rudimentaire manque de sensibilité et seules les bactéries capables de produire de grandes quantité d'acide à partir du lactose (en pratique, Escherichia coli surtout) donnent un résultat clairement positif[5]. Le caractère différentiel du milieu est considérablement amélioré par l'ajout de rouge neutre, un indicateur de pH de couleur orangée dans la gamme de pH initiale du milieu, dont le virage au rouge ne nécessite pas une acidification aussi intense que la précipitation des sels biliaires.
Le chlorure de sodium augmente la pression osmotique au sein du milieu. L'agar est l'agent gélifiant.
Lecture
L'aspect des colonies sur gélose MacConkey reflète leur aptitude à acidifier le lactose.
Les colonies qui acidifient le lactose (colonies « lactose + ») sont colorées en rose à rouge et rougissent le milieu environnant[7]. Elles peuvent être entourées d'un halo opaque provoqué par la précipitation des sels biliaires en milieu acide[5].
Les autres (colonies « lactose – ») sont incolores et ne modifient pas l'aspect du milieu.
Composition
Pour 1000 mL de milieu[7],[8] :
- peptone pancréatique de gélatine : 17 g
- lactose : 10 g
- chlorure de sodium : 5 g
- peptone pancréatique de caséine : 1,5 g
- peptone peptique de viande : 1,5 g
- sels biliaires : 1,5 g
- rouge neutre : 30 mg
- violet de gentiane : 1 mg
- agar : 13,5 g.
Ajuster le pH à 7,1 ± 0,2 à 25°C (après autoclavage).
Variantes
Selon les fournisseurs et les formulations :
- comme on l'a dit, les trois sortes de peptones peuvent être remplacées par 20 g/L d'une peptone quelconque[7],[8] ;
- la quantité d'agar peut varier de 12 à 15 g/L ;
- certains fabricants proposent des géloses MacConkey « n°2 » ou « n°3 » en fonction de la fraction raffinée de sels biliaires utilisée[9],[10] ;
- le chlorure de sodium peut être omis pour limiter l'essaimage (en) des colonies de Proteus[11].
La gélose MacConkey sorbitol ou SMAC (de l'anglais Sorbitol MAcConkey agar) est une variante dans laquelle le lactose est remplacé par une masse identique de sorbitol. Ainsi modifié, ce milieu est utile à la détection des Escherichia coli du sérotype O157:H7 dont la pathogénicité particulière est liée à la production de shigatoxines (STEC). En effet les E. coli O157:H7 se distinguent par leur incapacité à acidifier le sorbitol – qui se traduit par la formation de colonies incolores sur la gélose SMAC – tandis que les E.coli ordinaires acidifient le sorbitol et forment donc des colonies rouges. Cependant ce caractère n'a qu'une valeur d'orientation, la confirmation de l'identification devant être apportée par une technique plus précise telle qu'un sérotypage (dirigé contre les antigènes O157 et H7) ou une PCR.
La gélose MacConkey xylose ou Mac-X est une autre variante dans laquelle du xylose est ajouté à hauteur de 10 g/L[12]. Ce milieu facilite la détection des Shigella par la lecture facile de l'acidification du xylose, caractère habituellement négatif dans cette espèce (les colonies suspectes sont donc incolores)[13]. Les auteurs rapportent une positivité plus rapide de la réaction colorée, une sensibilité comparable et une spécificité supérieure ou égale à celle d'autres milieux de culture couramment utilisés pour détecter les Shigella (en particulier la gélose XLD).
Le milieu MacConkey se décline en version liquide, le bouillon MacConkey, utilisé pour la culture et l'identification des bactéries coliformes dans les eaux[14].
Préparation
Aucun ingrédient n'étant thermosensible, il suffit de les dissoudre à chaud dans le volume correspondant d'eau distillée et de stériliser à l'autoclave (15 min à 121°C). Le mélange est ensuite réparti dans des contenants stériles.
Notes et références
- 1 2 3 MacConkey AT « Note on a new medium for the growth and differenciation of the Bacillus coli communis and the Bacillus typhi abdominalis » Lancet 1900;156(4010):20. DOI 10.1016/S0140-6736(01)99513-3
- 1 2 MacConkey AT « Lactose-fermenting bacteria in faeces » J Hyg (Lond). 1905;5(3):333-379. DOI 10.1017/S002217240000259X
- 1 2 Grünbaum AS & Hume EH « Note on media for distinguishing B. coli, B. typhosus and related species » Br Med J. 1902;1(2163):1473-1474. DOI 10.1136/bmj.1.2163.1473
- ↑ Church DL « 3.3.1 Paratechnical Processing of Specimen for Aerobic Bacteriology » in: Leber AL (ed.) Clinical microbiology procedures handbook. Washington, DC : 4th ed, 2016, p. 3.3.1.1 (ISBN 9781555818807)
- 1 2 3 4 Smith KKP (2019) « The Origin of MacConkey Agar » sur le site de l'ASM, consulté le 28/03/2025.
- ↑ Corry JEL et al.. Handbook of culture media for food and water microbiology. Cambridge, UK : 3rd edition, 2011, RSC Publishing, p. 237. (ISBN 978-1-84755-916-6). DOI 10.1039/9781847551450.
- 1 2 3 4 « MacConkey Agar » in: Atlas RM. Handbook of media for environmental microbiology. Boca Raton : 2nd ed, 2005, CRC Press, Taylor & Francis Group, p. 295. (ISBN 9780849335600).
- 1 2 « MacConkey Agar » in: Atlas RM & Snyder JW. Handbook of media for clinical and public health microbiology. Boca Raton : 2014, CRC Press, Taylor & Francis Group, p. 282. (ISBN 978-1-4665-8293-4).
- ↑ « MacConkey Agar No. 2 (MacConkey Agar II) » in: Atlas RM & Snyder JW. Handbook of media for clinical and public health microbiology. Boca Raton : 2014, CRC Press, Taylor & Francis Group, p. 284. (ISBN 978-1-4665-8293-4).
- ↑ « MacConkey Agar No. 3 » in: Atlas RM & Snyder JW. Handbook of media for clinical and public health microbiology. Boca Raton : 2014, CRC Press, Taylor & Francis Group, p. 284. (ISBN 978-1-4665-8293-4).
- ↑ « MacConkey Agar without Salt » in: Atlas RM & Snyder JW. Handbook of media for clinical and public health microbiology. Boca Raton : 2014, CRC Press, Taylor & Francis Group, p. 284. (ISBN 978-1-4665-8293-4).
- ↑ Corry JEL et al.. Handbook of culture media for food and water microbiology. Cambridge, UK : 3rd edition, 2011, RSC Publishing, p. 294. (ISBN 978-1-84755-916-6). DOI 10.1039/9781847551450.
- ↑ Altwegg M et al. « Stool cultures for Shigella spp: improved specificity by using MacConkey agar with xylose » Diagn Microbiol Infect Dis. 1996;24(3):121-124. DOI 10.1016/0732-8893(96)00021-1.
- ↑ « MacConkey Broth » in: Atlas RM. Handbook of media for environmental microbiology. Boca Raton : 2nd ed, 2005, CRC Press, Taylor & Francis Group, p. 295. (ISBN 9780849335600).
Voir aussi
- Portail de la microbiologie